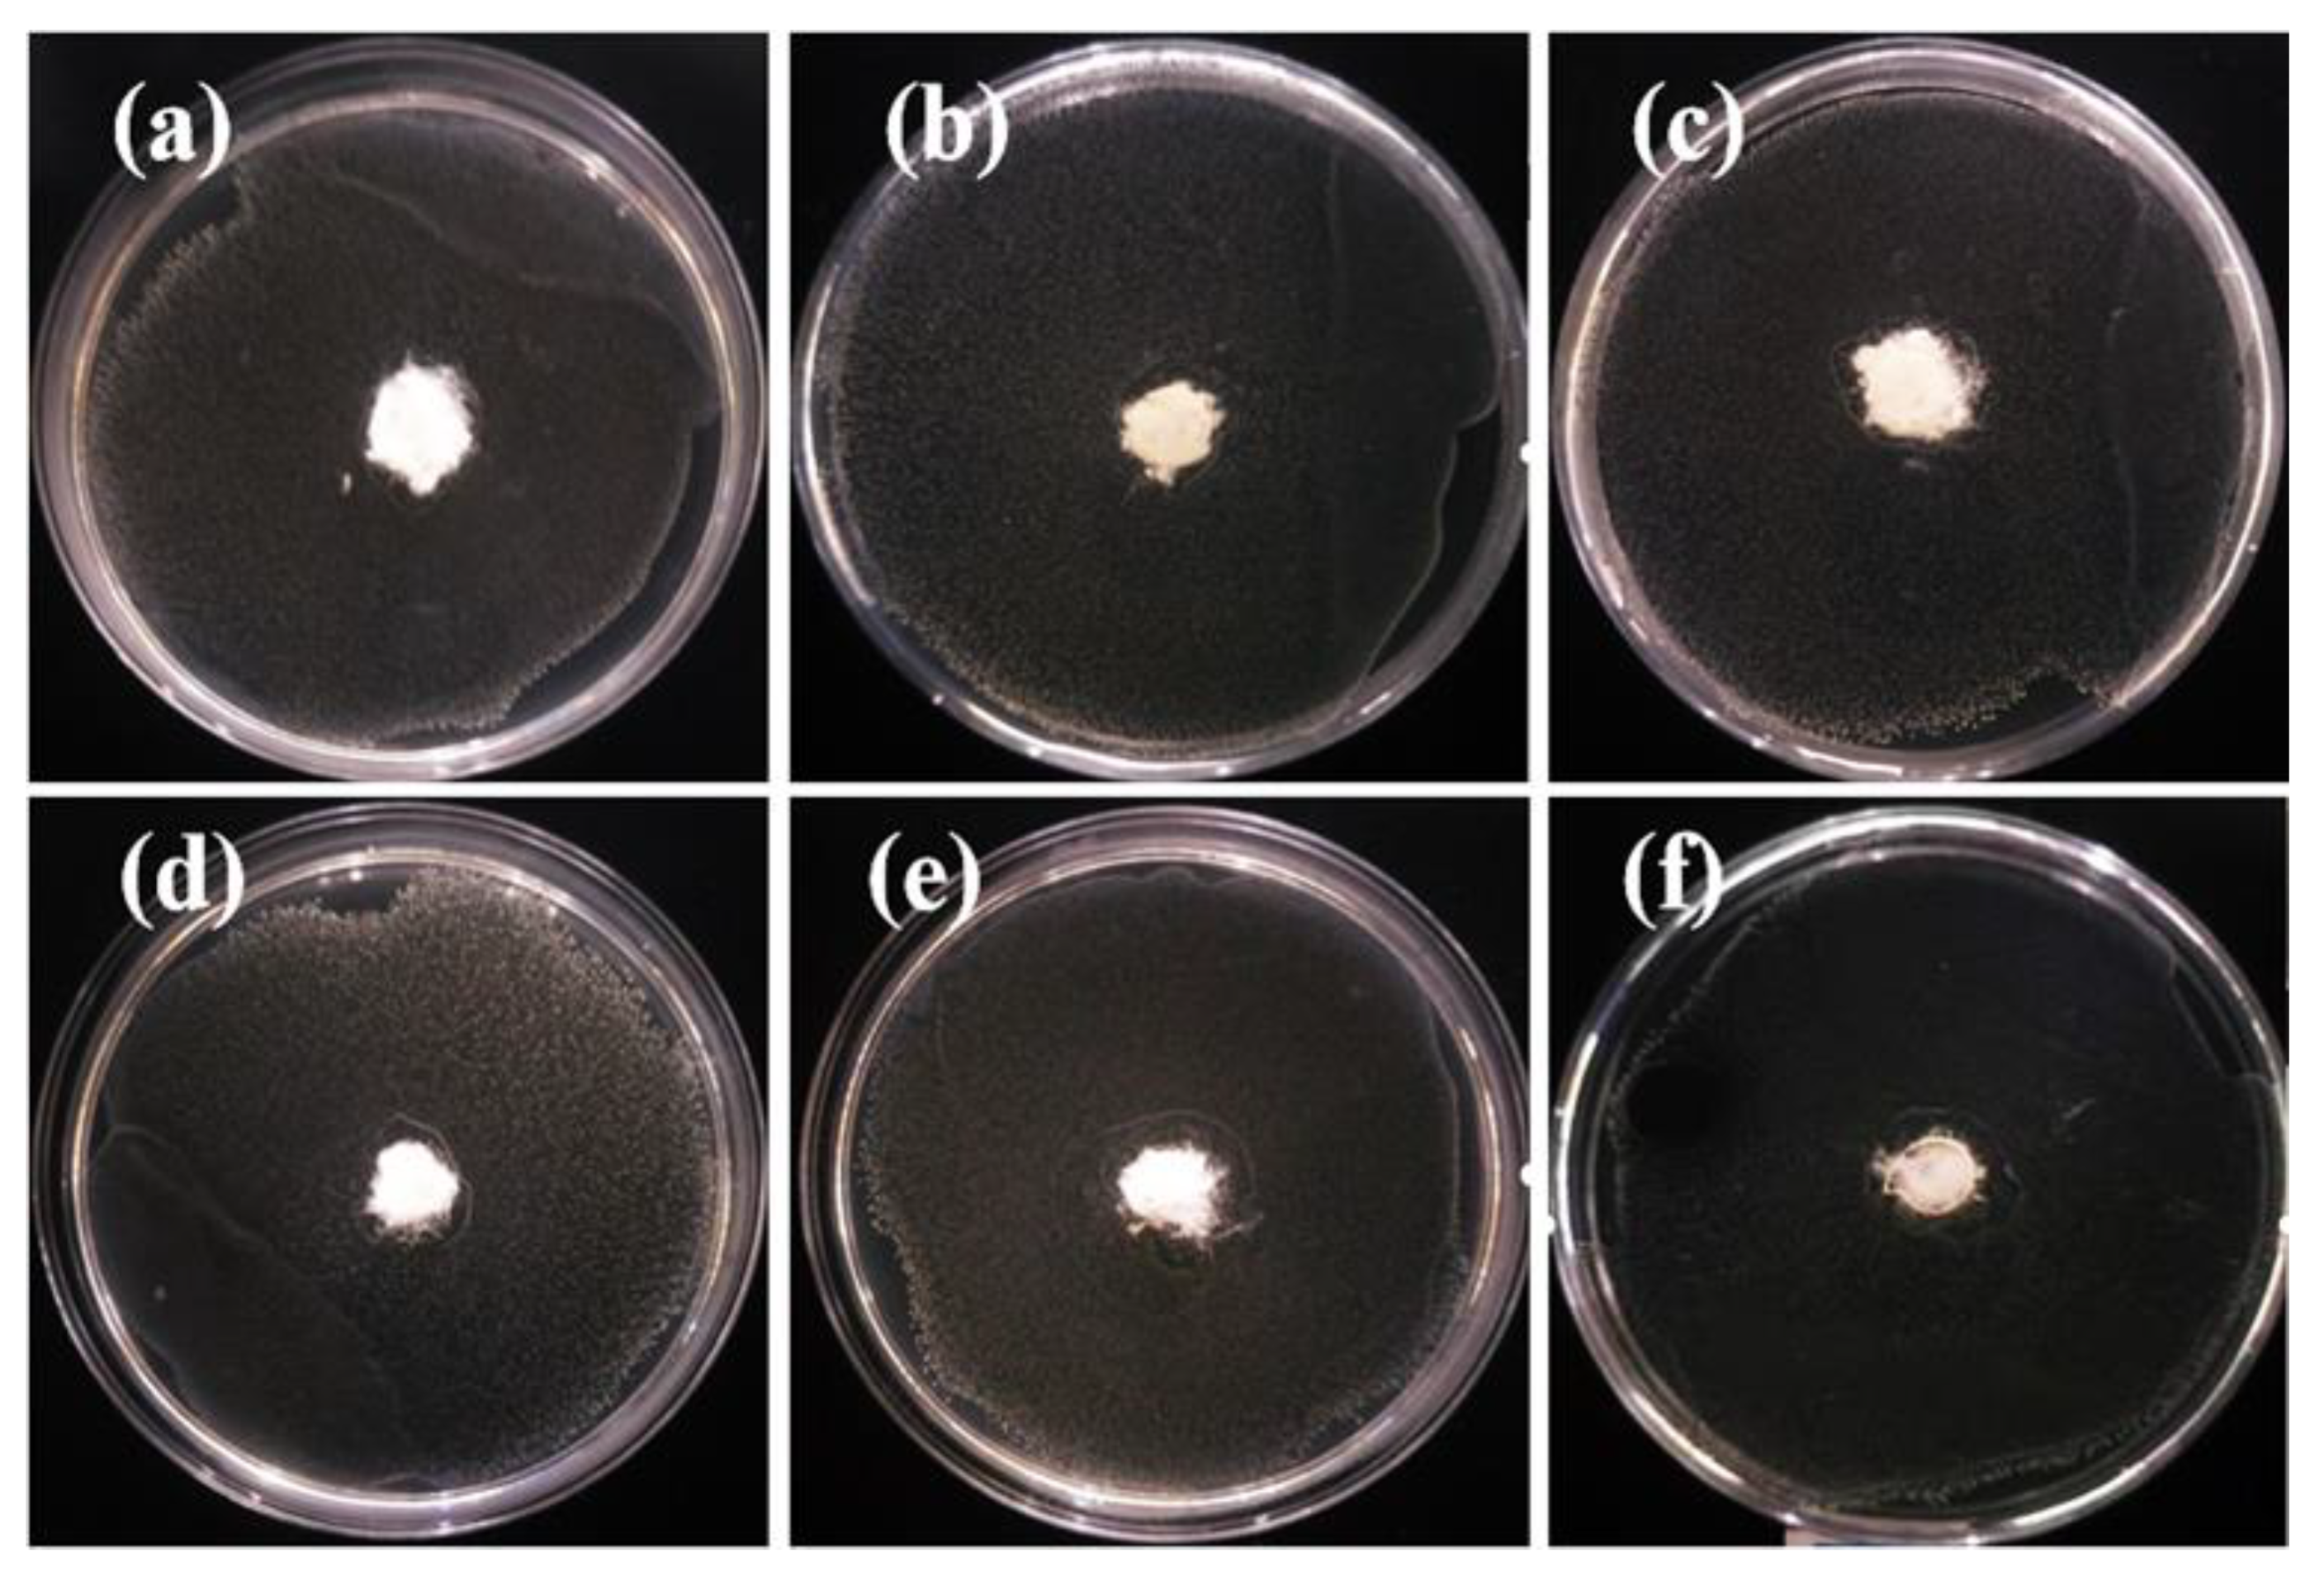
Polymers 12 00606 g009
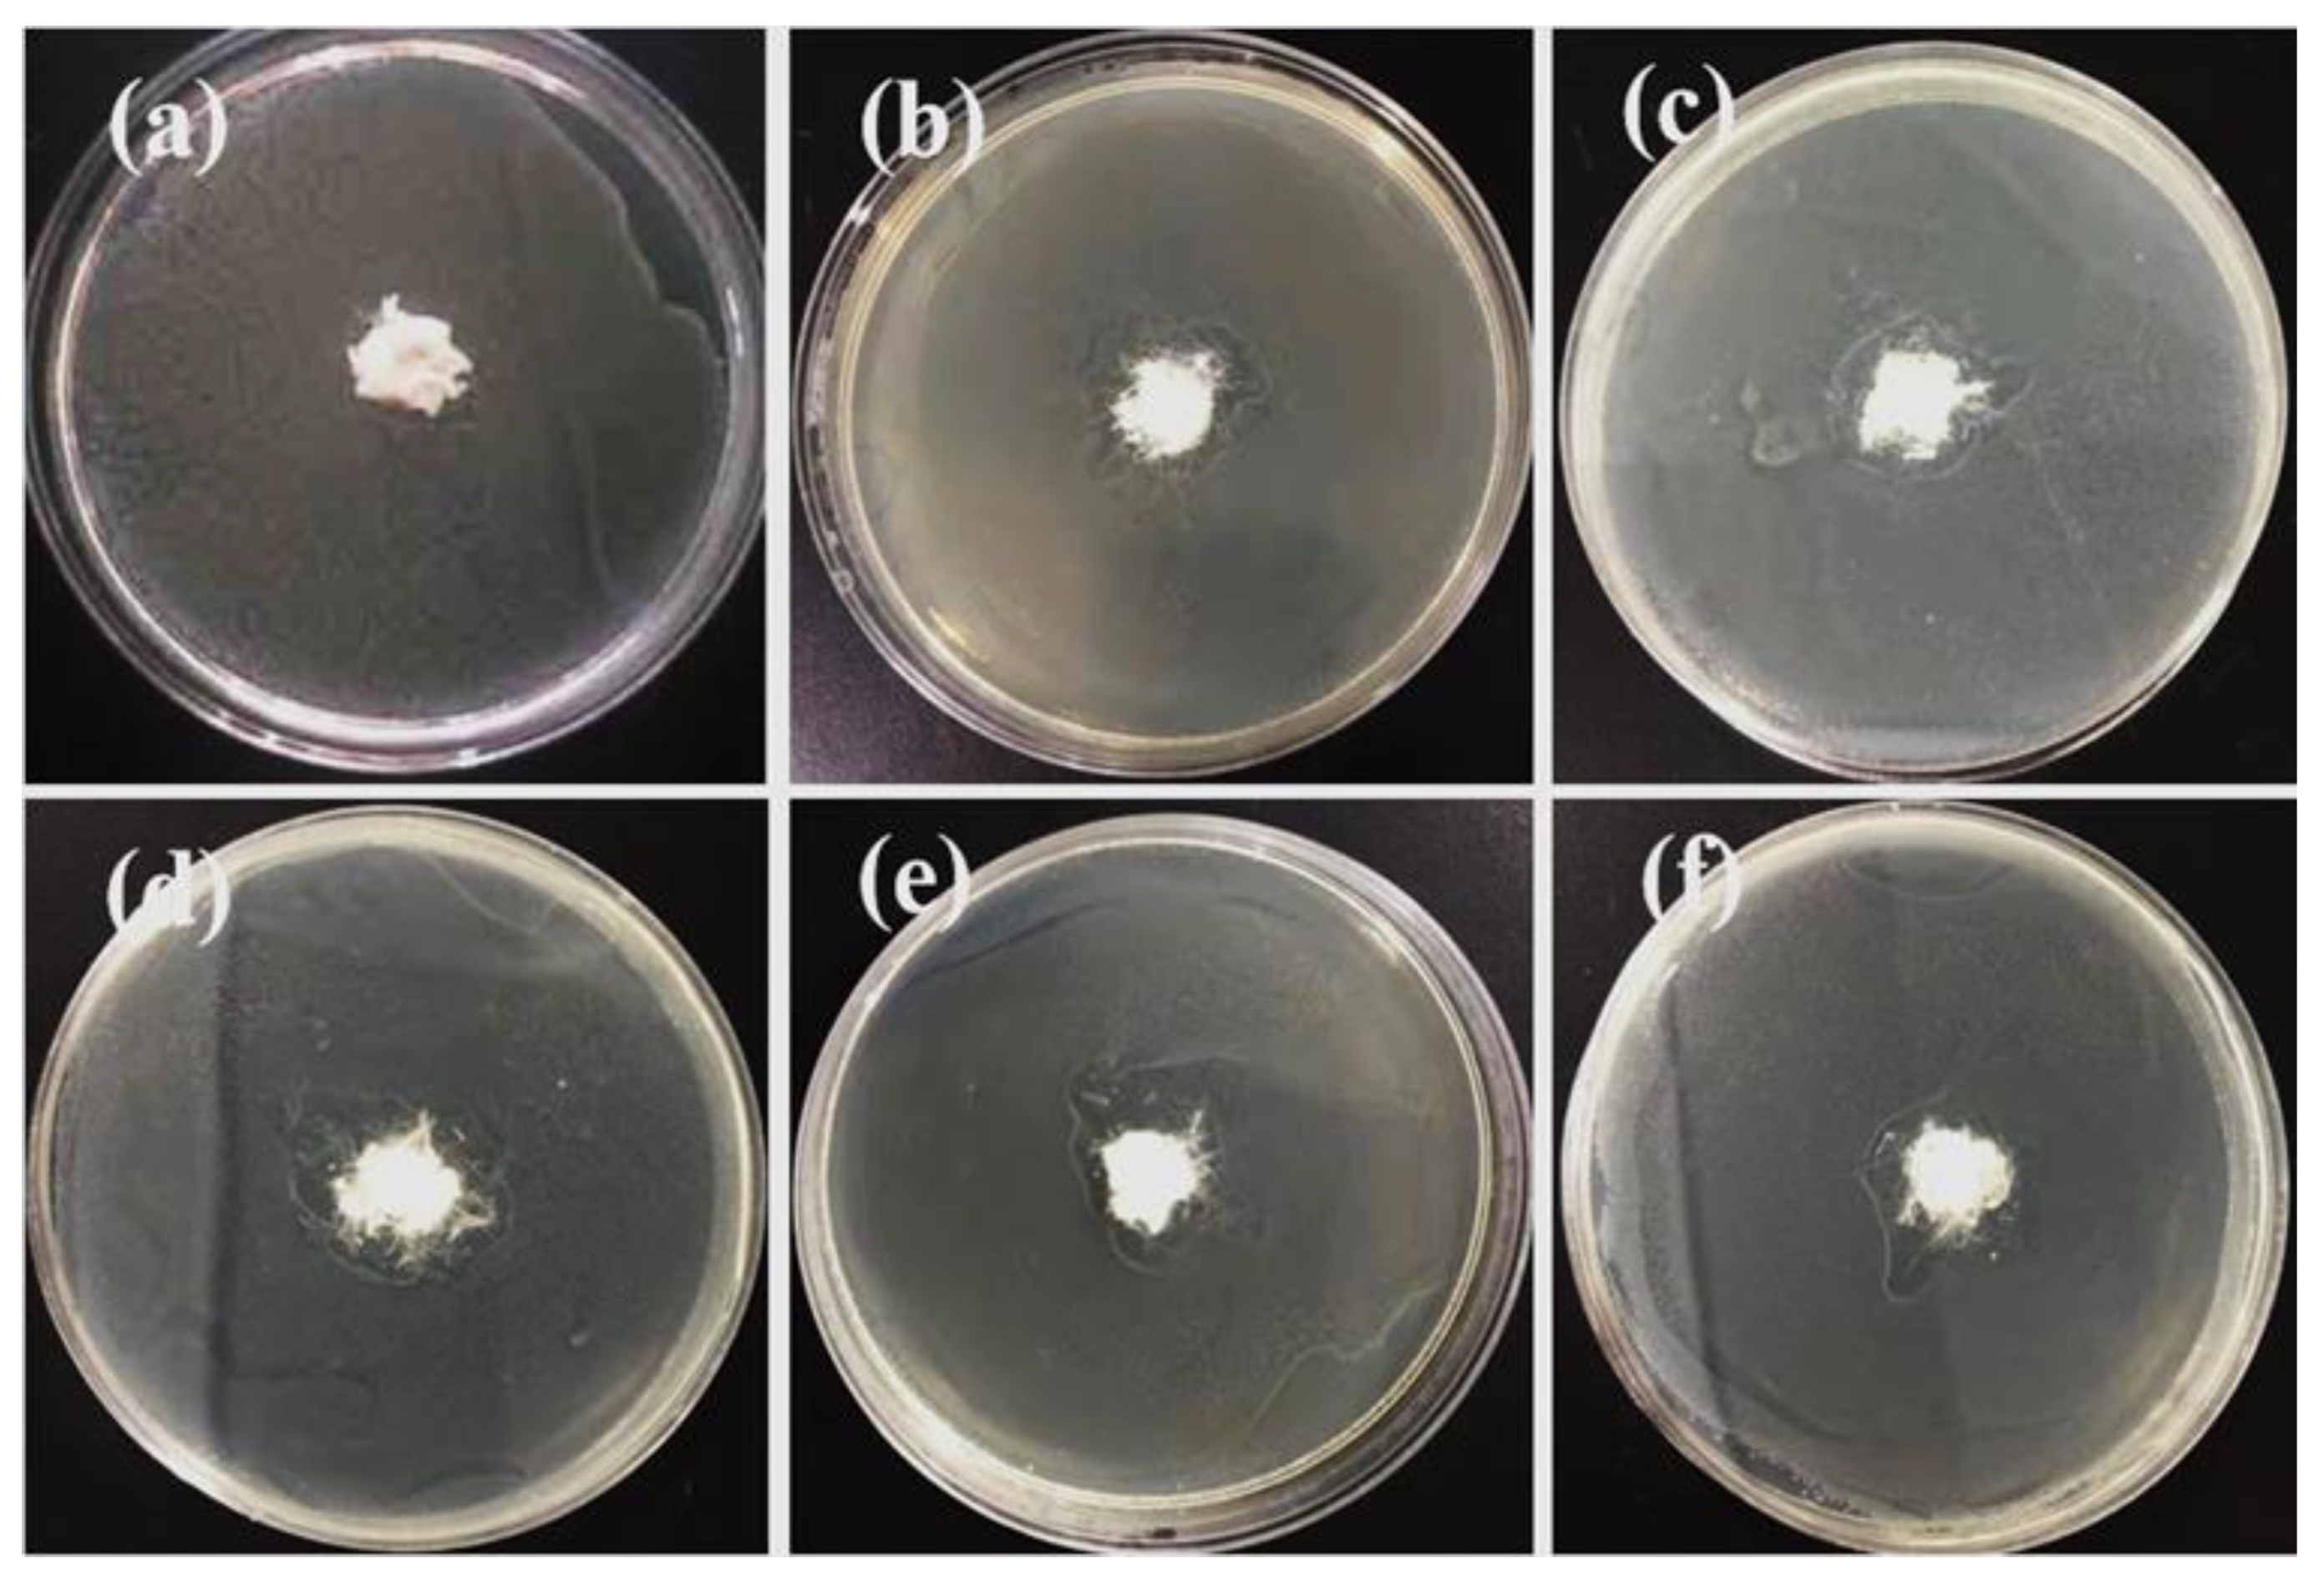
Polymers 12 00606 g010

Preparation and Performance of Ultra-Fine Polypropylene Antibacterial Fibers via Melt Electrospinning
Abstract
1. Introduction
2. Materials and Methods
2.1. Materials
2.2. Preparation of PP Antibacterial Masterbatches
2.3. Home-Made Melt E-Spinning Device
2.4. Characterization
3. Results and Discussion
3.1. Morphologies of PPS E-Spun Fibers
3.2. Thermal Properties of E-Spun PP Fiber
3.3. Mechanical Tensile Properties of E-Spun PP Fibers
3.4. Antibacterial Properties of E-Spun Fibers
4. Conclusions
Supplementary Materials
Author Contributions
Funding
Conflicts of Interest
References
- Utracki, L.A.; Dumoulin, M.M. Polypropylene alloys and blends with thermoplastics. In Polypropylene Structure, Blends and Composites; Springer: Dordrecht, The Netherlands, 1995; pp. 50–94. [Google Scholar] [CrossRef]
- Malkan, S.R. 9—Improving the use of polyolefins in nonwovens. In Polyolefin Fibres; Elsevier: Amsterdam, The Netherlands, 2017; pp. 285–311. [Google Scholar] [CrossRef]
- Majchrzycka, K.; Okrasa, M.; Brochocka, A.; Urbaniak-Domagala, W. Influence of Low-Temperature Plasma Treatment on the Liquid Filtration Efficiency of Melt-Blown PP Nonwovens in the Conditions of Simulated Use of Respiratory Protective Equipment. Chem. Process Eng. 2017, 195–207. [Google Scholar] [CrossRef]
- Li, Y.; Chen, G.; He, J.; Han, Y.; Wang, X.; Kaplan, D. Silk-Based Biomaterials in Biomedical Textiles and Fiber-Based Implants. Adv. Healthc. Mater. 2015, 4. [Google Scholar] [CrossRef]
- Peng, F.; Liu, D.; Zhao, W.; Zheng, G.; Ji, Y.; Dai, K.; Mi, L.; Zhang, D.; Liu, C.; Shen, C. Facile fabrication of triboelectric nanogenerator based on low-cost thermoplastic polymeric fabrics for large-area energy harvesting and self-powered sensing. Nano Energy 2019, 65, 104068. [Google Scholar] [CrossRef]
- Mirjalili, M.; Zohoori, S. Review for application of electrospinning and electrospun nanofibers technology in textile industry. J. Nanostruct. Chem. 2016, 6. [Google Scholar] [CrossRef]
- Cai, M.; He, H.; Zhang, X.; Yan, X.; Li, J.; Chen, F.; Yuan, D.; Ning, X. Efficient Synthesis of PVDF/PI Side-by-Side Bicomponent Nanofiber Membrane with Enhanced Mechanical Strength and Good Thermal Stability. Nanomaterials 2018, 9, 39. [Google Scholar] [CrossRef]
- Dong, W.-H.; Liu, J.-X.; Mou, X.-J.; Liu, G.-S.; Huang, X.-W.; Yan, X.; Ning, X.; Russell, S.J.; Long, Y.-Z. Performance of polyvinyl pyrrolidone-isatis root antibacterial wound dressings produced in situ by handheld electrospinner. Colloids Surf. B Biointerfaces 2020, 188, 110766. [Google Scholar] [CrossRef]
- Zhang, B.; Xu, Y.; He, H.-W.; Yu, M.; Ning, X.; Long, Y.-Z. Solvent-free Electrospinning: Opportunities and Challenges. Polym. Chem. 2016, 8. [Google Scholar] [CrossRef]
- Lian, H.; Meng, Z. Melt electrospinning vs. solution electrospinning: A comparative study of drug-loaded poly (ε-caprolactone) fibres. Mater. Sci. Eng. C 2017, 74. [Google Scholar] [CrossRef] [PubMed]
- He, H.-W.; Wang, L.; Xu, Y.; Zhang, L.-H.; Yu, M.; Yu, G.-f.; Dong, R.; Xia, L.; Ramakrishna, S.; Long, Y.-Z. Solvent-free electrospinning of UV curable polymer microfibers. RSC Adv. 2016, 6. [Google Scholar] [CrossRef]
- Liu, S.-L.; Long, Y.-Z.; Huang, Y.-Y.; Zhang, H.-D.; He, H.-W.; Sun, B.; Sui, Y.-Q.; Xia, L.-H. Solventless electrospinning of ultrathin polycyanoacrylate fibers. Polym. Chem. 2013, 4. [Google Scholar] [CrossRef]
- He, H.-W.; Zhang, B.; Xu, Y.; Dong, R.; Jia, X.; Yu, G.-f.; Ning, X.; Xia, L.; Long, Y.-Z. Solvent-free thermocuring electrospinning to fabricate ultrathin polyurethane fibers with high conductivity by in situ polymerization of polyaniline. RSC Adv. 2016, 6. [Google Scholar] [CrossRef]
- Zhang, L.-H.; Duan, X.-P.; Xu, Y.; Yu, M.; Ning, X.; Zhao, Y.; Long, Y.-Z. Recent Advances in Melt Electrospinning. RSC Adv. 2016, 6. [Google Scholar] [CrossRef]
- Fan, Z.-Z.; He, H.-W.; Yan, X.; Zhao, R.-H.; Long, Y.-Z.; Ning, X. Fabrication of Ultrafine PPS Fibers with High Strength and Tenacity via Melt Electrospinning. Polymers 2019, 11, 530. [Google Scholar] [CrossRef] [PubMed]
- Hutmacher, D.; Dalton, P. Melt Electrospinning. Chem. Asian J. 2011, 6, 44–56. [Google Scholar] [CrossRef] [PubMed]
- Nayak, R.; Padhye, R.; Kyratzis, I.; Truong, Y.; Arnold, L. Effect of viscosity and electrical conductivity on the morphology and fiber diameter in melt electrospinning of polypropylene. Text. Res. J. 2013, 83, 606–617. [Google Scholar] [CrossRef]
- Kadomae, Y.; Maruyama, Y.; Sugimoto, M.; Taniguchi, T.; Koyama, K. Relation between tacticity and fiber diameter in melt-electrospinning of polypropylene. Fibers Polym. 2009, 10, 275–279. [Google Scholar] [CrossRef]
- Cho, D.; Zhou, H.; Cho, Y.; Audus, D.; Joo, Y. Structural properties and superhydrophobicity of electrospun polypropylene fibers from solution and melt. Poly 2010, 51, 6005–6012. [Google Scholar] [CrossRef]
- Shim, M.; Philippe, G.-S. Organic-Capped ZnO Nanocrystals: Synthesis and n-Type Character. J. Am. Chem. Soc. 2001, 123, 11651–11654. [Google Scholar] [CrossRef]
- Becheri, A.; Dürr, M.; Lo Nostro, P.; Baglioni, P. Synthesis and characterization of zinc oxide nanoparticles: Application to textiles as UV-absorbers. J. Nanopart. Res. 2008, 10, 679–689. [Google Scholar] [CrossRef]
- AbdElhady, M. Preparation and Characterization of Chitosan/Zinc Oxide Nanoparticles for Imparting Antimicrobial and UV Protection to Cotton Fabric. Int. J. Carbohydr. Chem. 2012. [Google Scholar] [CrossRef]
- Sharma, D.; Rajput, J.; Kaith, B.S.; Kaur, M.; Sharma, S. Synthsis of ZnO nanoparticals and study of their antibacterial and antifungal properties. Thin Solid Films 2010, 519, 1224–1229. [Google Scholar] [CrossRef]
- Li, J.H.; Hong, R.; Li, M.; Li, H.Z.; Zheng, Y.; Ding, J. Effects of ZnO nanoparticles on the mechanical and antibacterial properties of polyurethane coatings. Prog. Org. Coat. 2009, 64, 504–509. [Google Scholar] [CrossRef]
- Schilling, K.; Bradford, B.; Castelli, D.; Dufour, E.; Nash, J.; Pape, W.; Schulte, S.; Tooley, I.; Bosch, J.; Schellauf, F. Human Safety Review of “nano” Titanium Dioxide and Zinc Oxide. Photochem. Photobiol. Sci. 2010, 9, 495–509. [Google Scholar] [CrossRef] [PubMed]
- Kuo, J.; Fan, C.-C.; Su, T.-L.; Chen, S.-H.; Lan, W. Nano composite fiber process optimization for polypropylene with antibacterial and far-infrared ray emission properties. Text. Res. J. 2016, 86. [Google Scholar] [CrossRef]
- Malis, D.; Jeršek, B.; Tomšič, B.; Štular, D.; Golja, B.; Kapun, G.; Simončič, B. Antibacterial Activity and Biodegradation of Cellulose Fiber Blends with Incorporated ZnO. Materials 2019, 12, 3399. [Google Scholar] [CrossRef]
- Espitia, P.J.P.; Soares, N.d.F.F.; Coimbra, J.S.d.R.; de Andrade, N.J.; Cruz, R.S.; Medeiros, E.A.A. Zinc Oxide Nanoparticles: Synthesis, Antimicrobial Activity and Food Packaging Applications. Food Bioprocess Technol. 2012, 5, 1447–1464. [Google Scholar] [CrossRef]
- Fakoori, E.; Karami, H. Preparation and characterization of ZnO-PP nanocomposite fibers and non-woven fabrics. J. Text. Inst. 2018, 109, 1–7. [Google Scholar] [CrossRef]
- Rodríguez-Tobías, H.; Morales, G.; Ledezma, A.; Romero, J.; Grande, D. Novel antibacterial electrospun mats based on poly(D,L-lactide) nanofibers and zinc oxide nanoparticles. J. Mater. Sci. 2014, 49. [Google Scholar] [CrossRef]
- Tijing, L.; Ruelo, M.; Amarjargal, A.; Pant, H.; Park, C.-H.; Kim, D.; Kim, C. Antibacterial and superhydrophilic electrospun polyurethane nanocomposite fibers containing tourmaline nanoparticles. Chem. Eng. J. 2012, 197, 41–48. [Google Scholar] [CrossRef]
- Augustine, R.; Malik, H.; Kumar, D.; Mukherjee, A.; Malakar, D.; Kalarikkal, N.; Thomas, S. Electrospun polycaprolactone/ZnO nanocomposite membranes as biomaterials with antibacterial and cell adhesion properties. J. Polym. Res. 2014, 21. [Google Scholar] [CrossRef]
- Rodríguez-Tobías, H.; Morales, G.; Grande, D. Electrospinning and Electrospraying Techniques for Designing Antimicrobial Polymeric Biocomposite Mats. Nanofiber. Res. 2016, 5, 91–106. [Google Scholar]
- Nakaoki, T.; Yamanaka, T.; Ohira, Y.; Horii, F. Dynamic FT-IR Analysis of the Crystallization to the Planar Zigzag Form for Syndiotactic Polypropylene. Macromolecules 2000, 33. [Google Scholar] [CrossRef]
- Awad, A.; Elgamsy, R.; El-Wahab, A.; Hazem Abdellatif, M. Mechanical behavior of PP reinforced with marble dust. Constr. Build. Mater. 2019, 228, 116766. [Google Scholar] [CrossRef]
- Bai, J.; Liao, X.; Huang, E.; Luo, Y.; Yang, Q.; Li, G. Control of the cell structure of microcellular silicone rubber/nanographite foam for enhanced mechanical performance. Mater. Des. 2017, 133, 288–298. [Google Scholar] [CrossRef]
- Joe, A.; Park, S.H.; Shim, K.D.; Kim, D.J.; Jhee, K.H.; Lee, H.W.; Heo, C.H.; Kim, H.M.; Jang, E.S. Antibacterial mechanism of ZnO nanoparticles under dark conditions. J. Ind. Eng. Chem. 2017, 45, 430–439. [Google Scholar] [CrossRef]
- Shi, L.E.; Li, Z.H.; Zheng, W.; Zhao, Y.F.; Jin, Y.F.; Tang, Z.X. Synthesis, antibacterial activity, antibacterial mechanism and food applications of ZnO nanoparticles: A review. Food Addit. Contam. Part A 2014, 31, 173–186. [Google Scholar] [CrossRef]
- Ong, C.B.; Ng, L.Y.; Mohammad, A.W. A review of ZnO nanoparticles as solar photocatalysts: Synthesis, mechanisms and applications. Renew. Sustain. Energy Rev. 2018, 81, 536–551. [Google Scholar] [CrossRef]
- Ton, N.Q.T.; Le, T.N.T.; Kim, S.; Dao, V.A.; Yi, J.; Vu, T.H.T. High-Efficiency Photo-Generated Charges of ZnO/TiO2 Heterojunction Thin Films for Photocatalytic and Antibacterial Performance. J. Nanosci. Nanotechnol. 2020, 20, 2214–2222. [Google Scholar] [CrossRef]

| Heating Zones | 1 | 2 | 3 | 4 | 5 | 6 | 7 | 8 | 9 | 10 |
| Temperature (°C) | 170 | 180 | 190 | 200 | 200 | 210 | 210 | 210 | 210 | 210 |
© 2020 by the authors. Licensee MDPI, Basel, Switzerland. This article is an open access article distributed under the terms and conditions of the Creative Commons Attribution (CC BY) license (http://creativecommons.org/licenses/by/4.0/).
Share and Cite
Li, Q.-S.; He, H.-W.; Fan, Z.-Z.; Zhao, R.-H.; Chen, F.-X.; Zhou, R.; Ning, X. Preparation and Performance of Ultra-Fine Polypropylene Antibacterial Fibers via Melt Electrospinning. Polymers 2020, 12, 606. https://doi.org/10.3390/polym12030606
Li Q-S, He H-W, Fan Z-Z, Zhao R-H, Chen F-X, Zhou R, Ning X. Preparation and Performance of Ultra-Fine Polypropylene Antibacterial Fibers via Melt Electrospinning. Polymers. 2020; 12(3):606. https://doi.org/10.3390/polym12030606
Chicago/Turabian StyleLi, Qiu-Sheng, Hong-Wei He, Zuo-Ze Fan, Ren-Hai Zhao, Fu-Xing Chen, Rong Zhou, and Xin Ning. 2020. "Preparation and Performance of Ultra-Fine Polypropylene Antibacterial Fibers via Melt Electrospinning" Polymers 12, no. 3: 606. https://doi.org/10.3390/polym12030606
APA StyleLi, Q.-S., He, H.-W., Fan, Z.-Z., Zhao, R.-H., Chen, F.-X., Zhou, R., & Ning, X. (2020). Preparation and Performance of Ultra-Fine Polypropylene Antibacterial Fibers via Melt Electrospinning. Polymers, 12(3), 606. https://doi.org/10.3390/polym12030606

